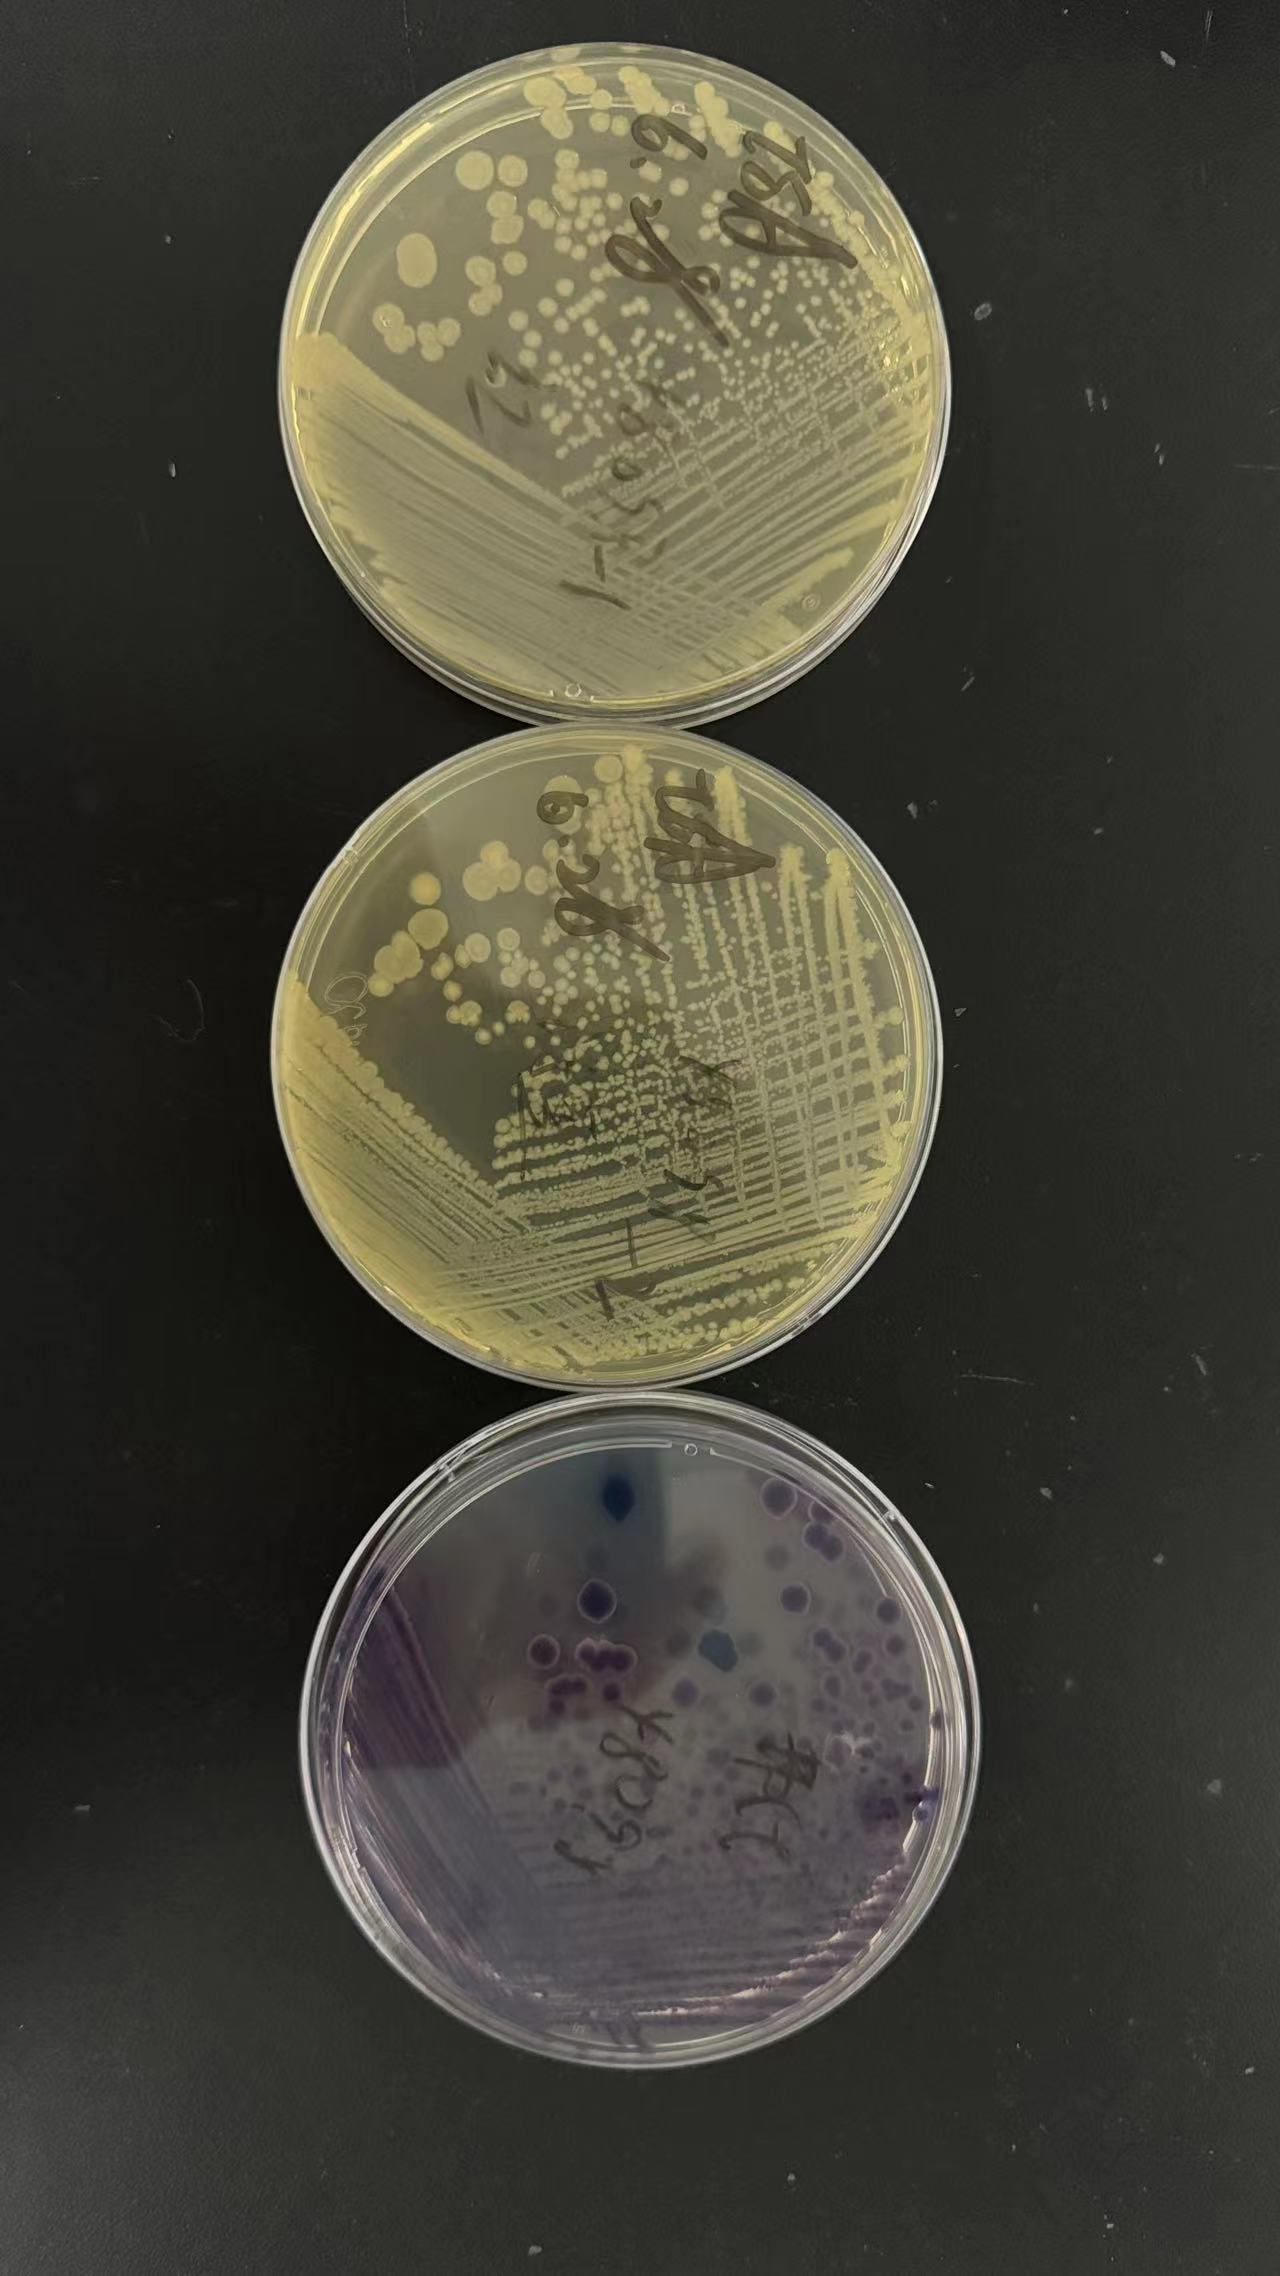
菌种接种平板后不长的原因分析！

菌种接种平板后不长的原因分析!
2024-09-02 14:35点击次数:1212
关键词:我们做微生物实验的时候,常用平板接种菌落,经常会遇到在给平板接种菌之后却没有菌落生长的情况。今天,我们来分析一下出现这种情况的原因。本文将从菌种、人员操作、培养基和添加剂三个方面来分析。
一、菌种原因
1,菌种老化:菌种如果经过连续频繁的传代达十几次甚至几十次,就会造成菌种老化,岀现生长缓慢甚至不生长的情况。
2,野生菌种:相比于标准菌株,有一些野生分离的菌种本身比较脆弱,对营养要求比较高,对外界不良环境也比较敏感,难以在普通的平板上生长,往往需要加入特殊的营养物质。
3,菌种没有进行充分活化:当我们拿到一株菌的时候,该菌种往往是处于一个保藏状态的,这就需要我们通过合适的培养基来逐代扩大培养,得到活力旺盛的菌株,所以充分活化的目的就是要让菌种逐渐适应培养环境,从而在平板上快速生长。
4,样品中的菌:有的样品中本身含菌量就较少,如水样、供试液等,接种量低造成平板上无菌生长。还有的样品中含有一些抑菌成分,会杀死样品中的菌,导致无菌落生长。
5,购买的商品化菌株:有一些商品化的菌株,如益生菌、菌肥、可食用真菌等,本身进行过基因改造,不能进行连续传代扩大培养,故在平板上难以生长。
二、人员操作不当
1、容器未洗刷干净,残留的抑菌成分导致菌不生长。
2、培养基配置过程中称量错误,加入添加剂比例错误等。
3、过度灭菌,有很多培养基成分不耐高温,过度灭菌会导致成分失效。
4、调pH值错误,不同温度下培养基的pH值也会不一样,未正确的调配pH值,也会导致菌不生长。
5、在实验操作过程中失误,特别是在稀释菌液过程中少接或者错接菌。
6、未放置合适的培养条件,根据不同菌对氧气的需求程度,可以分为需氧、厌氧、微需氧培养等。根据不同菌对温度的需求,又可以在25°C、30°C、35°C、42°C、56°C等不同温度下培养。
三、培养基及添加剂原因
1、成品培养基本身质量不好,如原材料纯度不高、含有抑菌成分、原材料之间配比错误等都会导致成品培养基不合格。
2、特殊培养基及添加剂未正确存放,未遮光、冷藏、严格密封保存等导致失效。
3、培养基及添加剂超过有效期或者临近有限期,营养成分存在一定程度的失效导致菌不生长。
4、培养基及添加剂营养不够或者不适合培养某类菌种。有一些菌种本身营养要求比较特殊,需要添加某些特殊营养后方能生长。
5、培养基pH值发生改变,有一些特殊的成品培养基pH值随时间会存在一定程度的改变,在使用前需要对pH值重新进行调整,否则也会导致菌不生长。

本周
本月
本年
LetPub发布最新SCI影响因子查询及期刊投稿分析系统
ELISpot试剂盒限时特惠!一口价低至500元,加赠免费读板服务
草甘膦(glyphosate)酶联免疫分析(ELISA)试剂盒使用说明书
链脲佐菌素 (Streptozotocin,STZ)-糖尿病动物模型造模
LetPub完整SCI影响因子、期刊分区查询系统
淋巴细胞百分比偏低原因解析
应用gentleMACS™灌流技术从脂肪肝小鼠模型高效分离肝细胞与非实质细胞
研究思路 | 多组学专题——如何进行转录组+蛋白组关联分析?
单个细胞也能提取核酸?超全干货教你微量样本发高分(含完整电子版宝典资料))
如何正确使用基因/蛋白质的名称格式(大写与斜体的使用)
- 促销公告
- 更多 ›


